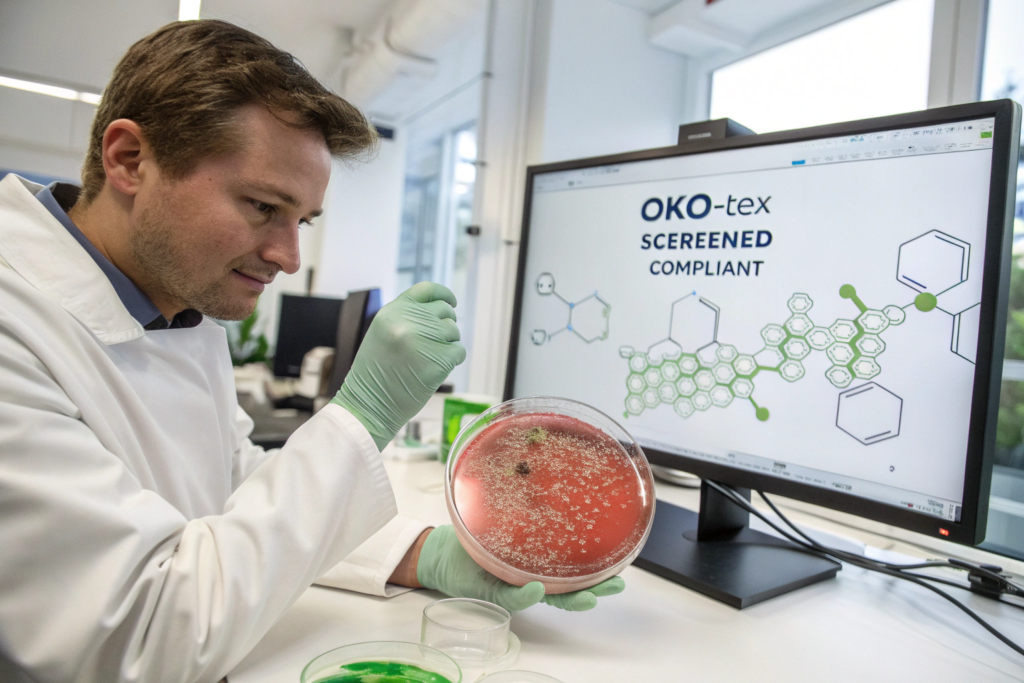

You're pushing the boundaries of ski apparel: developing bio-based membranes, integrating wearable tech, and exploring self-healing fabrics. In this race for the next big innovation, a critical question arises: Will OEKO-TEX certification become a relic of the past, or will it evolve to be the essential gatekeeper for the future of safe, sustainable, and high-performance ski wear?
The future of OEKO-TEX in ski apparel innovation is one of deeper integration and expanded scope. It will evolve from a baseline safety filter to an active enabler and verifier of next-generation materials and circular systems. OEKO-TEX will not just react to innovation but will proactively shape it by defining the safety parameters for bio-engineered fabrics, smart textiles, and closed-loop recycling, ensuring that breakthrough performance never compromises human or planetary health.
The certification body is already on this path. The future isn't about whether OEKO-TEX will be relevant, but how it will become indispensable in validating the responsible advancement of ski apparel technology. Let's explore the key frontiers.
How Will OEKO-TEX Adapt to Bio-Based and Novel Material Innovations?
The quest for alternatives to petroleum-based synthetics is driving R&D in materials like algae-based polyester, spider-silk inspired proteins, and fermented mycelium leather. These novel substances present unknown chemical profiles and potential new allergens or toxins.
OEKO-TEX's future role will be to establish the toxicological assessment framework for these materials. This means:
- Expanding Testing Parameters: Developing new test methods to screen for biological metabolites, fermentation residues, or unique binding agents used in these processes.
- Lifecycle Assessment Integration: Moving beyond just finished product safety to consider the environmental impact of novel material production (water use, GMOs, energy), potentially linking more closely with the STeP and MADE IN GREEN labels.
- Building a "Positive List" for Bio-Chemistry: Instead of just restricting harmful substances, potentially curating a list of approved, safe bio-based chemicals and processes for textile application.
For a brand pioneering a ski jacket with a bio-derived waterproof membrane, having OEKO-TEX certification will be the critical proof that this exciting new material is not only performative but also toxicologically vetted. It will de-risk adoption for consumers and retailers. At Shanghai Fumao, we are already engaging with mills developing these next-gen materials and asking the forward-looking question: "What is your plan for OEKO-TEX certification?" This positions us and our clients at the forefront of safe innovation.
What about performance enhancers like graphene or carbon nanotubes?
These nano-materials are being explored for thermal regulation and strength. Their long-term human and environmental effects are a major debate. OEKO-TEX is likely to develop specific, strict regulations for nanoparticles, testing for their potential to release from fabrics and their biological impact. Certification will become the essential control point to ensure these powerful technologies are used safely, preventing a future "asbestos of textiles" scenario. Brands using such tech will need OEKO-TEX to legitimize their safety claims scientifically.
How will this affect development timelines and costs?
Innovation with certification in mind will require closer R&D partnerships between brands, material scientists, and OEKO-TEX institutes from the very beginning. This may extend initial development phases but will prevent costly dead-ends where a revolutionary material fails safety tests late in the game. The cost of "certification-by-design" will become a standard line item in advanced material R&D budgets.
What Role Will OEKO-TEX Play in the Smart & Connected Ski Suit Ecosystem?
As discussed in a previous article, smart textiles are certifiable today. In the future, as suits become more integrated—with body-metric sensors, adaptive climate control, and augmented reality displays—OEKO-TEX's role will expand to become the system integrator of safety.
The future certification may look at:
- Cross-Material Compatibility: Ensuring that the chemicals in a conductive ink don't react with a new polymer coating to create a new harmful substance.
- Durability of Safety Under Stress: Testing smart systems not just when new, but after simulated extended use, washing, and flexing to ensure no degradation leads to chemical leaching.
- Energy Source Safety: Certifying the chemical safety of new types of flexible batteries, solar cell layers, or piezoelectric generators integrated into the textile.
OEKO-TEX could evolve a modular certification, where a smart fabric base, a sensor module, and a power unit each have sub-certifications, and the final assembled product receives a holistic "System Certification." This would provide clarity in a complex component supply chain.

Will it address data and privacy concerns?
OEKO-TEX is a chemical and physical safety standard. Data privacy (e.g., from a biometric ski suit) falls under regulations like GDPR and is outside its scope. However, the trust established through its product safety certification may make consumers more receptive to adopting connected wearables from a brand they already trust for material integrity.
How Will It Drive and Validate the Circular Economy?
The future of sustainability is circular. OEKO-TEX is positioning itself to be the verification backbone for circular flows, ensuring they are not just efficient, but also clean.
- Certification for Advanced Recycling Inputs: As chemical recycling of textiles (breaking polymers down to monomers) scales up, the input stream's chemical purity is paramount. OEKO-TEX certification of pre-consumer or post-consumer feedstock will guarantee it is free from contaminants that could disrupt recycling or carry toxins into new products. This creates a certified circular material value chain.
- "Design for OEKO-TEX Recyclability" Guidelines: We may see OEKO-TEX issuing guidelines for designers, akin to "Design for Disassembly," but focused on chemical compatibility. For example: "To achieve OEKO-TEX Circularity Certification, avoid combining polyester shells with PVC-based prints, as they create hazardous byproducts during chemical recycling."
- Linking MADE IN GREEN to Circular Loops: The MADE IN GREEN label, with its traceable ID, could be used to track a garment's journey not just from factory to consumer, but from consumer back to recycler and into a new product. This provides an unprecedented level of lifecycle transparency.
For a brand marketing a ski jacket as "fully circular," having OEKO-TEX certifications at every stage—from virgin (or recycled) material, to production (STeP), to the final product (STANDARD 100), and even for its recycled output—will be the only credible way to prove the claim. It turns a linear certificate into a circular passport.

How will this impact sourcing and manufacturing?
Factories of the future, like our vision for Shanghai Fumao, will need to be circular-ready hubs. This means not only using certified inputs but also having systems to handle take-back programs, partner with certified recyclers, and potentially integrate some pre-processing of end-of-life garments. Our role will expand from manufacturer to material lifecycle manager for our brand partners.
What Regulatory and Consumer Trends Will Shape Its Evolution?
OEKO-TEX does not operate in a vacuum. It responds to and often anticipates regulatory and market shifts.
- The "Forever Chemicals" Crackdown: Global regulations on PFAS/PFCs are tightening rapidly. OEKO-TEX STANDARD 100 already has strict limits. Its future evolution will likely involve banning entire substance classes earlier than legislation, pushing the industry toward safer alternatives faster. Brands aligned with OEKO-TEX will be regulatory-proof.
- Digital Product Passports (DPPs) in the EU: The upcoming EU DPP regulation will require a digital record of a product's composition, durability, and environmental impact. The data generated for OEKO-TEX MADE IN GREEN and detailed test reports will be a perfect, ready-made foundation for compliance, making certification more valuable than ever.
- Consumer Demand for "Radical Transparency": Future consumers will scan a QR code and expect to see not just a certificate, but batch-level test results, factory audit scores, and carbon footprint data. OEKO-TEX's digital platforms are poised to deliver this, transforming the certificate from a static PDF into an interactive trust interface.

How should brands prepare for this future?
The strategy is threefold:
- Innovate with Certification in Mind: Engage OEKO-TEX or informed manufacturers early when developing new materials or technologies.
- Invest in Full Transparency: Move beyond STANDARD 100 to STeP and MADE IN GREEN to build a comprehensive data asset for future regulations and marketing.
- Choose Future-Ready Partners: Align with suppliers whose capabilities and philosophy match this trajectory. At Shanghai Fumao, we are investing in the systems, partnerships, and expertise to navigate this future with our clients, turning compliance from a cost into a competitive accelerator.
Conclusion
The future of OEKO-TEX in ski apparel innovation is dynamic and central. It will transition from being a compliance checkpoint to becoming an integral partner in responsible innovation—setting the safety rules for new material sciences, validating the integrity of circular systems, and providing the data backbone for digital transparency.
For visionary ski brands, this means OEKO-TEX certification will no longer be about keeping up with the competition, but about leading the responsible future of the industry. By embracing its evolving role, brands can ensure that their most groundbreaking innovations are also their most trusted, building a legacy of performance that honors both people and the planet.
Innovate with foresight and responsibility. Partner with a manufacturer who is planning for this future today. At Shanghai Fumao, we are building the capabilities to help you navigate the next generation of safe, sustainable, and certified ski apparel. Contact our Business Director, Elaine, to future-proof your brand. Reach her at elaine@fumaoclothing.com.














